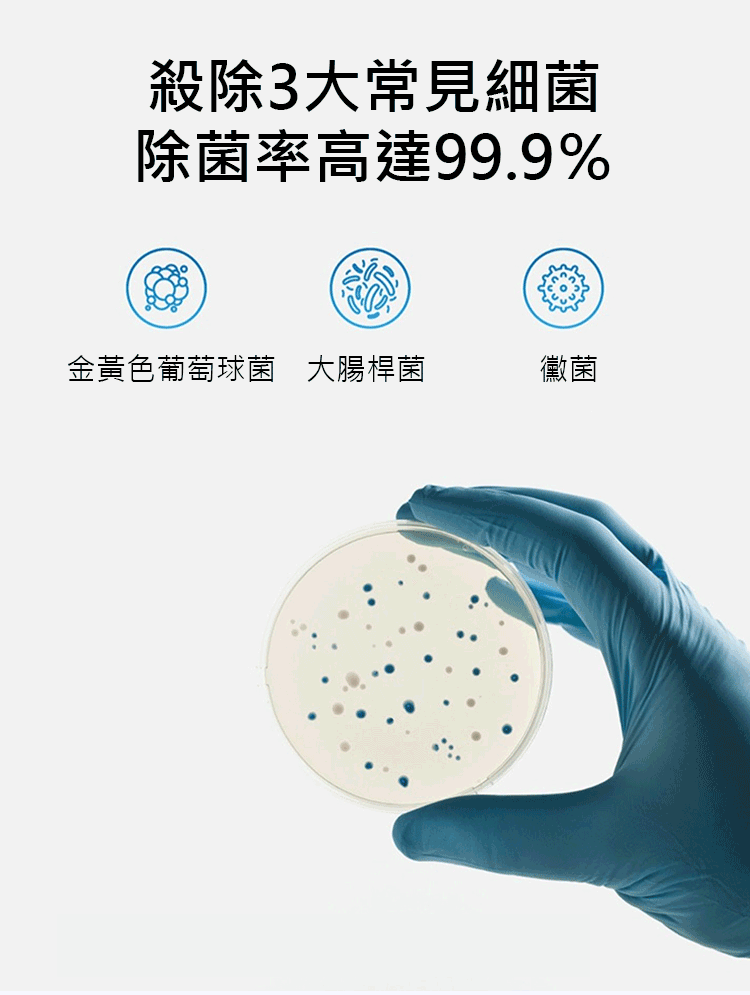

【清洁小能手】全自動智能掃地機器人,大吸力 + 強續航,一次完成吸塵+拖地
【懶人救星】不用自己動手,它就能把家裡打掃得乾乾淨淨!會自己規劃路線,桌底、床底都能鑽進去掃。吸力超強,頭髮、灰塵、餅乾屑統統吸走,還能順便拖地,地板亮晶晶!沒電了自己回去充電,充完繼續掃。手機一點就能指揮它工作,超方便!工作起來安安靜靜,不會吵到人。
NT$890
NT$1,483
優惠 NT$593
數量
本店致力於保護您的個人訊息,請放心使用
台灣出貨,預計1-2日內發貨,3-7日送達。
支持7-11取貨,填寫超商地址即可
支持貨到付款,14天鑒賞期,24小時客服